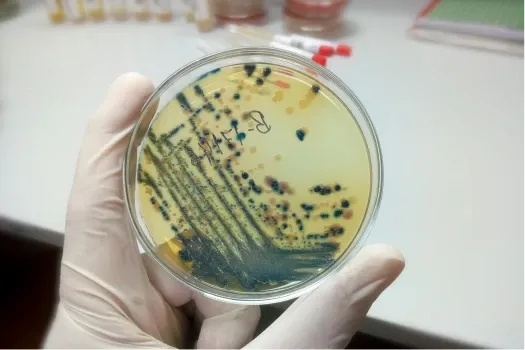
Microbiología y Parasitología

Admisión de Posgrado 2025-I
Impulsa tu carrera profesional y domina el campo laboral con los programas que tenemos para ti.
Cierre de inscripciones: 28 de marzo del 2025
Conoce nuestras carreras, encuentra tu vocación
Ver más informaciónEventos
Posgrado
Explora nuestros laboratorios, potenciadores de la investigación
Producción Científica de la Facultad

Gonzalo Chávez Corcuera, Roxana Castañeda, Harol Gutiérrez y John Ocampo
Artículo científico | Passiflora albopurpurea, a new species of sect. Granadillastrum (Passifloraceae, subg. Passiflora) discovered in the central montane forest of Peru

Jaemy Romero-Herrada, Eduardo Nycander, Bruno Díaz, César Arana y Letty Salinas.
Arículo científico / Temporal Dynamics of Parental Behavior and Nest Use in Ara chloropterus and Ara macao at an Artificial Nest Box in Peru

Piero Mazzei, Miguel Machahua, José Roque, Asunción Cano
Artículo científico | Nototriche nawiyoc (Malvoideae, Malvaceae), a new species with trifid sepal apices from the Andes of Huancavelica, Peru
Camila Castillo Vilcahuaman, Roger Alberto Palomino Huarcaya, Pedro Sepúlveda Rebolledo y Maribel Baylon Coritoma
Metabarcoding Analysis Reveals Microbial Diversity and Its Environmental Drivers in the Pantanos de Villa Lagoons in Lima—Peru

Convenios
Los convenios de cooperación con instituciones líderes en salud y biotecnología nos permiten actualizar y mejorar nuestros programas educativos y de investigación, facilitando el acceso de nuestros estudiantes a tecnologías avanzadas y metodologías innovadoras. Los convenios con redes de salud permiten a los estudiantes aplicar sus conocimientos en entornos profesionales reales y de alta demanda, teniendo un impacto directo y positivo en la sociedad.